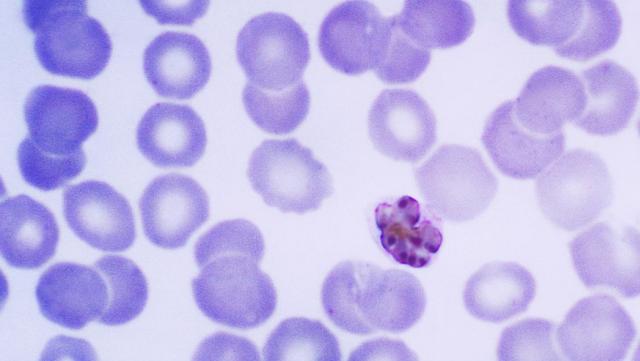
Monkeys Are Spreading Malaria in Malaysia

The 4 Ms- Majority, Monkeys, Malaria and Malaysia!!!
The majority of malaria hospitalisations in Malaysia are now caused by a dangerous and potentially deadly monkey-borne parasite once rarely seen in humans, according to a research by a Malaysia-based Indian scholar.

Deforestation is the potential culprit in a growing number of infections that could allow this virulent malaria strain to jump from macaque monkeys to human hosts, showed the research.
"This is a form of malaria that was once rarely seen in people, but today, in some remote areas of the country, all of the indigenous malaria cases we are seeing are caused by the P. knowlesi parasite," said Balbir Singh, director, Malaria Research Centre at University of Malaysia, Sarawak.
"If the number of cases continue to increase, human-to-human transmission by mosquitoes becomes possible. In fact, this may already have happened, which would allow P. knowlesi malaria to spread more easily throughout southeast Asia," cautioned Singh.
The infections are concentrated in areas of Malaysia where over the last decade massive loss of native forest to timber and palm oil production has led to substantially increased human interactions with macaques, the research showed.
That puts knowlesi malaria in the elite group of emerging and re-emerging diseases - including Ebola and AIDS - that are being passed from animals to humans as development peels back more and more layers of tropical forest previously uninhabited by humans, pointed out the research.
The parasite causes only mild malaria in macaques, but in people it is the fastest replicating malaria parasite, multiplying every 24 hours in the blood, pointed out Singh.
"Controlling a zoonotic - meaning an animal-to-human infection - carried by outdoor feeding mosquitoes is almost impossible with currently used methods," noted Singh.
The findings were presented at the American Society of Tropical Medicine and Hygiene's annual meeting.
No comments:
Post a Comment
Follow me on Twitter: @toyeenbsworld
Instagram: @toyeenbsworlddubai
Facebook: www.facebook.com/ToyeenB
YouTube: Oluwatoyin Balogun